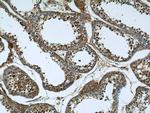
KIFC1 Antibody in Immunohistochemistry (Paraffin) (IHC (P))

Search
Proteintech
KIFC1 Polyclonal Antibody
{{$productOrderCtrl.translations['antibody.pdp.commerceCard.promotion.promotions']}}
{{$productOrderCtrl.translations['antibody.pdp.commerceCard.promotion.viewpromo']}}
{{$productOrderCtrl.translations['antibody.pdp.commerceCard.promotion.promocode']}}: {{promo.promoCode}} {{promo.promoTitle}} {{promo.promoDescription}}. {{$productOrderCtrl.translations['antibody.pdp.commerceCard.promotion.learnmore']}}
产品信息
20790-1-AP
种属反应
已发表种属
宿主/亚型
分类
类型
抗原
偶联物
形式
浓度
规格
纯化类型
保存液
内含物
保存条件
运输条件
产品详细信息
This antibody was raised against the C-terminal region of human KIFC1 protein, and recognizes 55-70 kDa of endogenous KIFC1 protein in multiple tissue lysates.
Immunogen sequence: GLLLFPSGP GGPSDPPTRL SLSRSDERRG TLSGAPAPPP RHDFSFDRVF PPGSGQDEVF EEIAMLVQSA LDGYPVCIFA YGQTGSGKTF TMEGGPGGDP QLEGLIPRAL RHLFSVAQEL SGQGWTYSFV ASYVEIYNET VRDLLATGTR KGQGGECEIR RAGPGSEELT VTNARYVPVS CEKEVDALLH LARQNRAVAR TAQNERSSRS HSVFQLQISG EHSSRGLQCG APLSLVDLAG SERLDPGLAL GPGERERLRE TQAINSSLST LGLVIMALSN KESHVPYRNS KLTYLLQNSL GGSAKMLMFV NISPLEENVS ESLNSLRFAS KVNQCVIGTA QANRK (382-725 aa encoded by BC000712)
靶标信息
Minus end-directed microtubule-dependent motor required for bipolar spindle formation (PubMed:15843429). May contribute to movement of early endocytic vesicles. Regulates cilium formation and structure. [UniProt]
仅用于科研。不用于诊断过程。未经明确授权不得转售。
生物信息学
蛋白别名: kifc1; kifc1 {ECO:0000312|EMBL:AAH83827.1, ECO:0000312|RGD:1359118}; kinesin family c-terminal 5A; kinesin motor protein KIFC4; kinesin-like 2; kinesin-like 2a; Kinesin-like protein 2; Kinesin-like protein KIFC1; Kinesin-related protein 1; Kinesin-related protein HSET; kinesin-related protein KIFC5A; kinesin-related protein KRP1; unnamed protein product
基因别名: HSET; 100042970; Gm4137; KIFC1; Kifc4; Kifc5a; Kifc5b; KNSL2; Knsl2a; Krp1; Tctex-7; Tctex-7A; Tctex7; Tctex7a
UniProt ID: (Human) Q9BW19, (Mouse) Q9QWT9, (Rat) Q5XI63
Entrez Gene ID: (Human) 3833, (Mouse) 100502766, (Rat) 294286